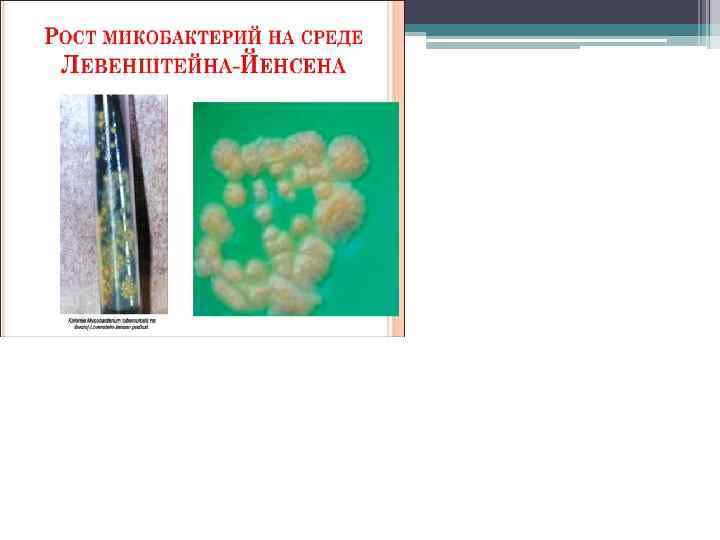

посев мокрты.pptx
- Количество слайдов: 24

Посев мокроты пригогтовила: Баймурадова Л Приняла: Омарова Г. Р

Введение. • На фоне напряженной эпидемической ситуации с заболеваемостью туберкулезом и наличия лекарственно-устойчивых форм M. Tuberculosis наиболее актуальными являются ускоренная диагностика туберкулеза и повышение эффективности определения лекарственной чувствительности культур микобактерий туберкулеза (МБТ) к противотуберкулезным препаратам. Выявление МБТ в разном патологическом материале от пациентов − ведущий признак для постановки диагноза заболевания туберкулезной этиологии. Определение лекарственной чувствительности МБТ чрезвычайно важно для характеристики эпидемиологической ситуации, прогнозирования течения туберкулезного процесса у конкретного больного, выбора рациональной схемы противотуберкулезной терапии и правильной оценки эффективности лечения. Самым надежным методом выявления возбудителя туберкулеза в мокроте или в других образцах является метод посева, который позволяет выявить МБТ при наличии в исследуемом материале нескольких сотен жизнеспособных особей.

• Туберкулез является инфекционным заболеванием, основным путем передачи которого является воздушно – капельный, поэтому из всех случаев туберкулеза более чем в 85% поражаются легкие. Туберкулез легких у взрослых в половине случаев имеет открытую (заразную) форму. Задачей специалистов сети ПМСП является скорейшее выявление заразного больного для его лечения и снижение распространения туберкулез ной инфекции в окружающей среде. Поэтому у всех пациентов с наличием кашля с мокротой, продолжающегося более 2 -х недель и других симптомов туберкулеза( боль в грудной клетке, потеря веса, потливость, кровохарканье длительное повышение температуры тела) необходимо заподозрить туберкулез и обязательно исследовать мокроту микроскопическим методом на наличие МБТ. Данный метод является простым, доступном и эффективным выявления туберкулеза и тем самом будет сделан первый шаг для защиты населения от распространения туберкулеза. Исследования должны быть проведены быстро (2 -3 дня), чтобы снизить риск распространения инфекции.


• Сбор мокроты: Для сбора мокроты рекомендуется использовать контейнеры из прочного материала, не пропускающего жидкости (у нас – это одноразовые контейнера из материала который легко утилизировать). Контейнеры должны быть прозрачными с широким горлышком (35 мм в диаметре) с плотно закрывающейся крышкой. Сбор мокроты с диагностической целью должен быть выполнен трехкратно по регламентированным правилам, согласно специальной инструкции. Пациент необходимо объяснить, как правильно собирать мокроту: 1. Мокроту следует собирать в специальной комнате с вентиляцией или на открытом воздухе. 2. Мокроту собирает утром до приема пиши. 3. Предварительно ополоснуть рот кипяченой водой. 4. Откашлять 5. Держать контейнер у самых губ и осторожно выплюнуть в него. 6. Плотно закрыть контейнер крышкой и передать медсестре. Если мокрота отделяется в скудном количестве, необходимо накануне сбора материала принять отхаркивающие средства. В случаях неправильного сбора мокроты диагноз может быть выставлен неверно, заболевание будет прогрессировать, и больной будет продолжать распространять инфекцию.

• Шаги сбора мокроты: 1. Одеть спецодежду( халат, колпак, фартук, маску – респиратор, перчатки). 2. Взять медицинскую форму ТБ 05 у пациента. 3. Ознакомить пациента с процедурой сбора мокроты (рассказать и попросить прочитать информацию). 4. Занести данные о пациенте из ТБ 05 в журнал сбора мокроты (левый част журнала). 5. Отметить имя пациента и номер образца на контейнере (только не на крышке). 6. Попросить пациента помыть руки, тщательно ополоснуть рот водой, чтобы удалить частицы пищи и загрязняющую микрофлору ротовой полости. 7. Поставить пациента лицом широко открытому окну. 8. Встать позади пациента на расстояние не менее 1 метра. 9. Попросить пациента откашлять 3 -5 мл мокроты и наблюдать за выполнением процедуры. 10. Предложить пациенту плотно закрыть контейнер закручивающейся крышкой и передать медсестре. 11. Убедиться в правильности закрытия контейнера, обработать его дезинфицирующим растворам и поставить в бикс. 12. Вымыть руки с мылом под проточной водой и обработать в соответствии с действующей инструкцией. 13. Выдать пациенту чистый контейнер для сбора мокроты дома утром следующего дня и попросить принести контейнер в кабинет сбора мокроты. 14. Предупредить пациента о необходимости сдачи третьего образца мокроты в кабинете сбора мокроты. 15. Отметить в журнале по сбору мокроты проведение процедуры (правый часть журнала) и отметить в ТБ 05 идентификационный номер образца.

• Транспортировка и хранение мокроты: Для транспортировки в лабораторию контейнеры с мокротой устанавливают в маркированный металлический бикс. Мокрота доставляется в лабораторию в течение суток, допускается хранение мокроты в медицинской организации до семи дней в холодильнике. К биксу прилагают сопроводительный документ, в котором приводят сведения о пациентах и пробах. Номер на каждом контейнере должен соответствовать идентификационному номеру в списке. При транспортировке биксы хранят в прохладном месте, защищенном от прямых солнечных лучей. Транспортировку мокроты осуществляют на транспорте медицинской организации в сопровождении медицинского работника. Бланки направлений на лабораторное исследование должны находиться отдельно от контейнеров в материалом.

• Бактериологический посев мокроты — тест используется для диагностики этиологического агента при инфекциях нижних дыхательных путей и диагностики туберкулеза легких. Из-за того, что мокрота часто загрязнена нормальной ротоглоточной флорой, присутствие этиологического агента трудно определить. • После идентификации этиологического агента определяется его чувствительность к антибиотикам.

Бактериоскопия и посев мокроты • • Для бактериоскопического исследования предварительно готовят препарат. Вначале растирают комок мокроты между двумя предметными стёклами; затем высохший мазок фиксируют над пламенем горелки и окрашивают: для поисков микобактерий туберкулёза по Цилю-Нильсену, в других случаях — по Грамму. Чувствительность бактериоскопического метода напрямую зависит от кратности обследования пациента. Например, согласно исследованиям, однократный анализ мокроты на микобактерии туберкулёза имеет чувствительность 8083%, двукратный анализ мокроты (в течение двух дней) — на 90 -93% больше и при исследовании трёх проб мокроты (в течение трёх дней) — 95 -98%. Таким образом, при подозрении на туберкулез органов дыхания необходимо исследовать не менее трёх проб мокроты. Отрицательный результат микроскопического исследования не исключает диагноз той или иной инфекции, так как мокрота пациента может содержать меньше микробов, чем может выявить микроскопическое исследование. Когда бактериоскопическое исследование не обнаруживает предполагаемого возбудителя, прибегают к посеву мокроты на питательные среды. Посев мокроты производят не позднее 2 -х часов после сбора. Если подозревается туберкулёз, то сбор мокроты осуществляют в течение 3 -х последовательных дней. Бактериологическое исследование позволяет идентифицировать вид микробов и определять их антибиотикочувствительность. Обычно у здоровых лиц в мокроте при посеве выявляются альфа-гемолитический стрептококк, Neisseria spp. , дифтероиды. Обнаружение лишь нормальной микрофлоры ещё не означает отсутствие инфекции. Результат посева следует интерпретировать с учётом клинической картины и общего состояния пациента. Критерием этиологической значимости возбудителя будет выявления микроба в концентрации 10 6 в 1 мл и выше. Но к выявлению микобактерий туберкулёза в любом количестве следует отнестись со всей серьёзностью.

• Первостепенной потребностью фтизиатров является сокращение времени получения результатов культурального исследования. Методом посева на плотную питательную среду Левенштейна − Йенсена (ЛЙ), являющимся «золотым стандартом» детекции микобактерий в практических лабораториях, видимый рост МБТ можно получить в лучшем случае на 28 – 32 день с момента посева, а средними сроками для выделения культуры являются 6 - 10 недель. С момента выделения культуры требуется ещё не менее 24 дней для определения лекарственной чувствительности МБТ методом абсолютных концентраций. • Длительные сроки получения результатов, обусловленные медленным ростом микобактериальной популяции, являются основным недостатком традиционных методов определения лекарственной чувствительности МБТ. На практике это означает, что химиотерапия больного туберкулезом в течение первых 2 – 3 месяцев проходит как бы «вслепую» , без учета чувствительности выделенных у больного МБТ к противотуберкулезным препаратам. На плотных средах ЛЙ методом абсолютных концентраций тестирование на лекарственную чувствительность МБТ занимает от 45 до 90 дней с момента посева, что удлиняет сроки лечения больного и увеличивает стоимость.

• Подготовка пациента к бактериологическому посеву мокроты • Забор мокроты осуществляют утром натощак. Перед откашливанием больной чистит зубы и полощет рот кипячёной водой. Мокроту для микробиологического исследования следует собрать до начала антибактериальной терапии. Желательно исследовать биоматериал из первой утренней порции. • При бронхоскопии вводится не более 5 мл физиологического раствора с последующей аспирацией в стерильный контейнер.

Посев материала на питательные среды. • Материал сеют на жидкие и твердые питательные среды. Международной является питательная среда Левенштейна. Йенсена. • Рост МБТ происходит на 15 -25 дни от момента посева.

• Получение чистой культуры МБТ позволяет посредством биохимических методик отличить МБТ от других микобактерий, определить их жизнеспособность, вирулентность и чувствительность к лекарственным препаратам. • Можно также оценить бактериовыделение: скудное – до 10 колоний на среде; умеренное - от 10 до 50; обильное – более 50 колоний.

Применение автоматизированного комплекса BACTEC MGIT – 960. • Регистрирует рост МБТ и определяет чувствительность к ХП на основе флюоресценции. • В аппаратах такого типа жидкая питательная среда содержит меченную 14 С пальмитиновую кислоту. Специальный сенсор улавливает признак роста МБТ по выделению 14 С уже через 10 -12 дней или раньше. • Другой принцип основан на поглощении кислорода в процессе роста МБТ. Уменьшение концентрации кислорода в закрытой камере активирует флюоресцентный индикатор, который начинает светится в ультрафиолетовых лучах.


• Исследованию данным методом подлежит следующий патологический материал: мокрота; -спинномозговая жидкость; -экссудаты; -операционный материал. Не исследуются кровь и моча. Вначале проводится исследование патологического материала на наличие МБТ люминисцентным методом, затем, в случае положительного результата, проводится анализ с использованием жидких питательных сред и прибора BACTEC MGIT 960.

Группы пациентов, которым показан данный вид исследования: • впервые выявленные больные туберкулезом (однократно до начала химиотерапии); • больные с рецидивом туберкулеза (однократно до начала химиотерапии); • больные с менингитом (однократно до начала химиотерапии); • больные с распространенным и остро прогрессирующим процессом (однократно до начала химиотерапии); • дифференциально-диагностические больные (если необходимо, однократно); • контроль химиотерапии.

• Автоматизированная система позволяет получить результаты уже на 5 -12 -е сутки от момента посева диагностического материала. Однако, этот способ, будучи самым быстрым, одновременно является и наиболее дорогостоящим. • Прямой метод определения ЛУ с использованием среды Попеску позволяет получить результат в среднем на 20 -25 -й день от момента посева в отличие от 40 -60 -х дней, необходимых для получения результата при использовании традиционного метода абсолютных концентраций

• • • Принципиально новый уровень бактериологической диагностики туберкулеза достигнут внедрением в практику автоматизированных систем бульонного культивирования для ускоренного выявления микобактерий BACTEC MGIT 960 (“Becton Dickinson”) и MB/Bac. T (“Organon Teknika”), позволяющих выявлять рост культуры в диагностическом материале в течение 10 – 20 дней. Автоматизированная система BACTEC MGIT 960 зарекомендовала себя надежным методом микробиологической диагностики туберкулеза как в мире, так и во многих регионах. Эталонные исследования эффективности использования автоматизированных систем культивирования на жидких питательных средах BACTEC MGIT 960 и их преимуществ по сравнению с традиционным методом посева на плотные среды проведены в Московском городском научно - практическом Центре борьбы с туберкулезом под руководством доктора медицинских наук В. И. Литвинова. По данным авторов, чувствительность автоматизированной системы ВАСТЕС MGIT 960 по выделению культур МБТ оказалась на 10% выше традиционного способа посева на среду ЛЙ. Система BACTEC MGIT 960 продемонстрировала также более высокую высеваемость МБТ из бактериоскопически негативного материала, примерно на 15%, по сравнению с плотными средами. Для бактериоскопически позитивного материала чувствительность жидких и плотных сред для культивирования оказалась идентичной. По данным зарубежных исследователей, в автоматизированной системе ВАСТЕС MGIT 960 удалось получить примерно на 2, 2 – 4% больше изолятов МБТ из образцов мокроты, чем на плотной среде ЛЙ. Внедрение в практику бактериологических систем типа BACTEC MGIT 960 позволило сократить сроки выделения культуры МБТ. В среднем период культивирования образца на ВАСТЕС MGIT 960 составил 11 - 15, на плотной среде – 20 - 28 дней. Автоматизированная система BACTEC MGIT 960 позволила за относительно короткий период времени – в среднем за 2 недели − исследовать выделенные культуры микобактерий туберкулеза на чувствительность к противотуберкулезным препаратам (ПТП) первого ряда, в том числе к пиразинамиду [5, 7, 8]. Традиционным для определения лекарственной чувствительности (ЛЧ) к основным ПТП в России являлся метод абсолютных концентраций на плотной среде ЛЙ [9]. Система BACTEC MGIT-960 показывала значительное совпадение результатов тестирования чувствительности МБТ к антибактериальным препаратам с результатами, полученными методом абсолютных концентраций. Для рифампицина и изониазида совпадение данных о наличии чувствительных или резистентных форм МБТ составило 98, 5 и 98, 25% соответственно, для стрептомицина - 97, 26, для этамбутола - 93, 77%. При этом сроки получения результатов теста ЛЧ в автоматизированной системе BACTEC MGIT 960 составили от 4 до 13, тогда как по методу абсолютных концентраций – от 21 до 26 суток, что очень важно для своевременного и правильного выбора схемы противотуберкулезной терапии.

СПИСОК ЛИТЕРАТУРЫ • • • • Балабанова Я. М. и др. Использование автоматизированной системы ВАСТЕС MGIT 960 в диагностике лекарственной устойчивости к резервным препаратам в г. Самара// Туберкулез и болезни легких. 2009. № 9. С. 63 -70. Быкдарова К. Р. и др. Автоматизированная система ускоренной культуральной диагностики туберкулеза//Материалы VII Российского съезда фтизиатров. М. , 2003. С. 82 Диагностика и химиотерапия туберкулеза органов дыхания: Пособие для врачей. М. : Медицина и жизнь, 2003. 48 с. Иртуганова О. А. и др. Ускоренная культуральная диагностика туберкулеза с использованием автоматизированных систем ВАСТЕС MGIT 960 и МВ/ВАСТ//Пробл. туб. 2002. № 1. С. 58 – 62. Иртуганова О. А. и др. Определение чувствительности Mycobacterium tuberculosis к пиразинамиду на бактериальном анализаторе ВАСТЕС 960 // Пробл. туб. 2003. № 7. С. 40 – 42. Кондратюк Н. В. и др. Порiвняльна характеристика медикаментозноi чутливостi штамiв Mycobacterium tuberculosis // Мiкробiол. ж. 2006. Vol. 68, N 4. С. 54 -59 Лабораторная диагностика туберкулеза / Под ред. В. И. Литвинова, А. М. Мороза. М. : МНПЦБТ, 2001. 184 с. Малахов В. Н. и др. Качество бактериологического выявления и определения лекарственной чувствительности микобактерий туберкулеза участниками федеральной системы внешней оценки качества клинических лабораторных исследований в 2002 – 2003 гг. //Пробл. туб. 2005. № 4. С. 6 – 10. О совершенствовании противотуберкулезных мероприятий в Российской Федерации: Приказ МЗ РФ № 109 от 21. 03. 2003. Augustynowicz-Kopeć E. , Jaworski A. , Zwolska Z. Evaluation of Bactec MGIT 960 fluorescent method in diagnosis of tuberculosis//Pneumonol Alergol Pol. 2002; 70(9 -10): 450 -7. Chien H. P. et al. Comparison of the BACTEC MGIT 960 with Lowenstein-Jensen medium for recovery of mycobacteria from clinical specimens. // Int. J. Tuberc. Lung Dis. 2000 9: 866 -870. Laboratory Services in Tuberculosis Control. Geneva, WHO. 1998. Lee J. J. et al. Comparative evaluation of the BACTEC MGIT 960 system with solid medium for isolation of mycobacteriа //
посев мокрты.pptx